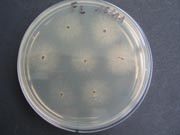
Rhizoctone brun 6.180

A propos des cookies
Qu’est-ce qu’un « cookie » ?
Un "cookie" est une suite d'informations, généralement de petite taille et identifié par un nom, qui peut être transmis à votre navigateur par un site web sur lequel vous vous connectez. Votre navigateur web le conservera pendant une certaine durée, et le renverra au serveur web chaque fois que vous vous y re-connecterez.
Différents types de cookies sont déposés sur les sites :
- Cookies strictement nécessaires au bon fonctionnement du site
- Cookies déposés par des sites tiers pour améliorer l’interactivité du site, pour collecter des statistiques
> En savoir plus sur les cookies et leur fonctionnement
Les différents types de cookies déposés sur ce site
Cookies strictement nécessaires au site pour fonctionner
Ces cookies permettent aux services principaux du site de fonctionner de manière optimale. Vous pouvez techniquement les bloquer en utilisant les paramètres de votre navigateur mais votre expérience sur le site risque d’être dégradée.
Par ailleurs, vous avez la possibilité de vous opposer à l’utilisation des traceurs de mesure d’audience strictement nécessaires au fonctionnement et aux opérations d’administration courante du site web dans la fenêtre de gestion des cookies accessible via le lien situé dans le pied de page du site.
Cookies techniques
Nom du cookie | Finalité | Durée de conservation |
|---|---|---|
Cookies de sessions CAS et PHP | Identifiants de connexion, sécurisation de session | Session |
Tarteaucitron | Sauvegarde vos choix en matière de consentement des cookies | 12 mois |
Cookies de mesure d’audience (AT Internet)
Nom du cookie | Finalité | Durée de conservation |
|---|---|---|
atid | Tracer le parcours du visiteur afin d’établir les statistiques de visites. | 13 mois |
atuserid | Stocker l'ID anonyme du visiteur qui se lance dès la première visite du site | 13 mois |
atidvisitor | Recenser les numsites (identifiants unique d'un site) vus par le visiteur et stockage des identifiants du visiteur. | 13 mois |
À propos de l’outil de mesure d’audience AT Internet :
L’outil de mesure d’audience Analytics d’AT Internet est déployé sur ce site afin d’obtenir des informations sur la navigation des visiteurs et d’en améliorer l’usage.
L‘autorité française de protection des données (CNIL) a accordé une exemption au cookie Web Analytics d’AT Internet. Cet outil est ainsi dispensé du recueil du consentement de l’internaute en ce qui concerne le dépôt des cookies analytics. Cependant vous pouvez refuser le dépôt de ces cookies via le panneau de gestion des cookies.
À savoir :
- Les données collectées ne sont pas recoupées avec d’autres traitements
- Le cookie déposé sert uniquement à la production de statistiques anonymes
- Le cookie ne permet pas de suivre la navigation de l’internaute sur d’autres sites.
Cookies tiers destinés à améliorer l’interactivité du site
Ce site s’appuie sur certains services fournis par des tiers qui permettent :
- de proposer des contenus interactifs ;
- d’améliorer la convivialité et de faciliter le partage de contenu sur les réseaux sociaux ;
- de visionner directement sur notre site des vidéos et présentations animées ;
- de protéger les entrées des formulaires contre les robots ;
- de surveiller les performances du site.
Ces tiers collecteront et utiliseront vos données de navigation pour des finalités qui leur sont propres.
Accepter ou refuser les cookies : comment faire ?
Lorsque vous débutez votre navigation sur un site eZpublish, l’apparition du bandeau « cookies » vous permet d’accepter ou de refuser tous les cookies que nous utilisons. Ce bandeau s’affichera tant que vous n’aurez pas effectué de choix même si vous naviguez sur une autre page du site.
Vous pouvez modifier vos choix à tout moment en cliquant sur le lien « Gestion des cookies ».
Vous pouvez gérer ces cookies au niveau de votre navigateur. Voici les procédures à suivre :
Firefox ; Chrome ; Explorer ; Safari ; Opera
Pour obtenir plus d’informations concernant les cookies que nous utilisons, vous pouvez vous adresser au Déléguée Informatique et Libertés de INRAE par email à cil-dpo@inrae.fr ou par courrier à :
INRAE
24, chemin de Borde Rouge –Auzeville – CS52627
31326 Castanet Tolosan cedex - France
Dernière mise à jour : Mai 2021